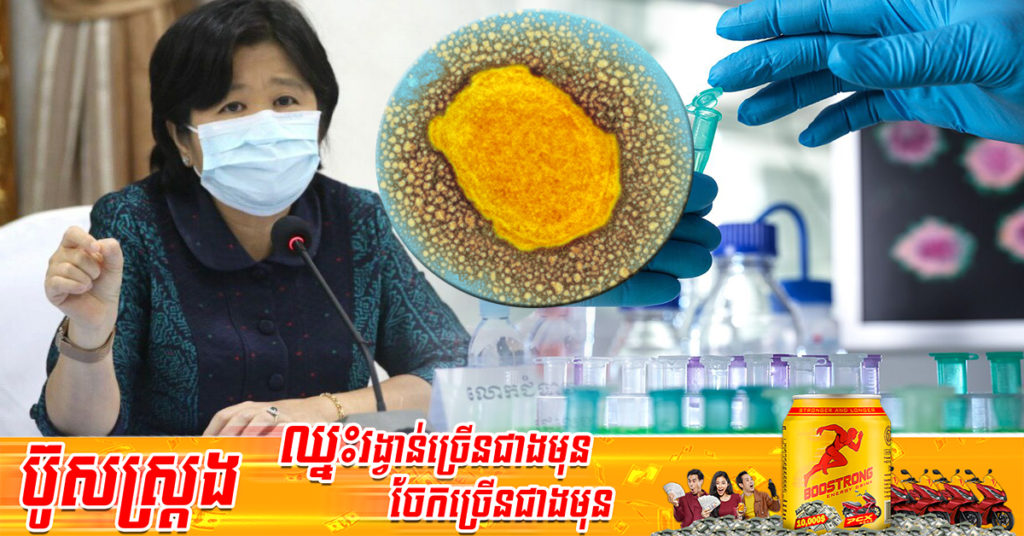
លោកជំទាវ ឱ វណ្ណឌីន ពន្យល់ពីស្ថានភាពនៃ «ការផ្ទុះឡើងជំងឺអុតស្វា» នៅលើសកលលោក ខណៈជំងឺនេះមិនទាន់កើតមាននៅកម្ពុជានៅឡើយទេ

លោកជំទាវ ឱ វណ្ណឌីន ពន្យល់ពីស្ថានភាពនៃ «ការផ្ទុះឡើងជំងឺអុតស្វា» នៅលើសកលលោក ខណៈជំងឺនេះមិនទាន់កើតមាននៅកម្ពុជានៅឡើយទេ
រាជធានីភ្នំពេញ៖ យោងតាមការចុះផ្សាយរបស់ ក្រសួងសុខាភិបាល នៅថ្ងៃទី២៣ ខែឧសភា ឆ្នាំ២០២២ បានចេញសេចក្ដីជូនដំណឹង ស្ដីពីស្ថានភាពនៃជំងឺអុតស្វា (Monkeypox) នៅលើសកលលោក ដែលផ្តើមចេញពីប្រទេសអង់គ្លេស។

លោកជំទាវវេជ្ជបណ្ឌិត ឱ វណ្ណឌីន រដ្ឋលេខាធិការ និងជាអ្នកនាំពាក្យក្រសួងសុខាភិបាល និងជាប្រធានគណកម្មការចំពោះចាក់វ៉ាក់សាំងកូវីដ-១៩ ក្នុងក្របខណ្ឌទូទាំងប្រទេស(គ.វ.ក-១៩) បានឲ្យដឹងថា ព្រឹកថ្ងៃទី២៣ ខែឧសភានេះ លោកស្រីបញ្ជាក់ថា រហូតមកដល់ពេលនេះ មិនទាន់មានករណីសង្ស័យ ឬ ករណីវិជ្ជមានជំងឺអុតស្វានេះ នៅកម្ពុជានៅឡើយទេ។
ទោះជាយ៉ាងណា លោកស្រីវេជ្ជបណ្ឌិត បានអំពាវនាវដល់ប្រជាជនដែលរស់នៅក្នុងព្រះរាជាណាចក្រកម្ពុជា ត្រូវមានការប្រុងប្រយ័ត្នខ្ពស់ជាប់ជានិច្ច ដោយបុគ្គល គ្រួសារ និងសហគមន៍ ត្រូវបន្តអនុវត្តវិធានការបង្ការជំងឺផ្ទាល់ខ្លួន។
ជាមួយគ្នា គ្រប់មន្ទីរពេទ្យ និងមណ្ឌលសុខភាពត្រូវតាមដាន និងរាយការណ៍ករណីសង្ស័យណាមួយ ដែលកើតមានឡើង ដើម្បីបន្តការស៊ើបអង្កេត។ ការពង្រឹងប្រព័ន្ធតាមដានជំងឺ នៅតាមមន្ទីរពេទ្យនានា ពិតជាមានសារៈសំខាន់ណាស់។
ជាមួយគ្នានេះ លោកស្រីបានជំរុញឲ្យយកចិត្តទុកដាក់ពិនិត្យមើលឱ្យបានហ្មត់ចត់ នូវអ្នកដំណើរចូលមកកម្ពុជា ដែលមានកន្ទួលរមាស់នៅលើខ្លួន អមដោយមានគ្រុនក្តៅ និងមានប្រវត្តិធ្វើដំណើរមកពីបណ្តាប្រទេសប៉ែកខាងអាហ្វ្រិក (ប្រមាណជា ១០ប្រទេស) ដែលមានការកើតឡើងនូវជំងឺអុតស្វា (Monkeypox) បែបជាអង់ដេមី ហើយត្រូវរាយការណ៍ទៅអាជ្ញាធរសុខាភិបាលភ្លាមៗ ឬទៅលេខ ១១៥៕





